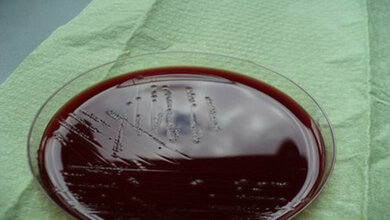
Labordiagnostik

Ein Herzmedikament gegen C. difficile?
Der gerade in den Krankenhäusern gefürchtete Keim C. difficile wurde erst Ende der 1970er-Jahre als Erreger von Durchfallerkrankungen in Zusammenhang mit Antibiotikabehandlung identifiziert [1]. Clostridioides (früher Clostridium) difficile verursacht circa 15–20 Prozent der Antibiotika-assoziierten Durchfallerkrankungen und mehr als 95 Prozent der Fälle von pseudomembranöser Kolitis [2]. „Der bakterielle Darmerreger Clostridioides difficile ist ein gefürchteter Krankenhauskeim, der insbesondere dann auftritt, wenn Patienten mit bestimmten Antibiotika behandelt werden“, erklärt Professor Panagiotis Papatheodorou vom Institut für Experimentelle und Klinische Pharmakologie, Toxikologie und Naturheilkunde des Ulmer Universitätsklinikums. „Weil diese Antibiotika jedoch viele nützliche Bakterien im Darm abtöten, ist dessen Mikrobiom, also die Gesamtheit der dort lebenden Mikroorganismen, gestört. So kann der Erreger sich im Darm ungehindert vermehren und seine Proteintoxine TcdA und TcdB ausscheiden.“ Diese Toxine dringen in die schützenden Epithelzellen auf der Darmoberfläche ein und schädigen sie, indem sie wichtige Schaltermoleküle inaktivieren. Dies verursacht Erkrankungen wie Antibiotika-assoziierte Diarrhoe oder gar die pseudomembranöse Kolitis, eine lebensbedrohliche Darmentzündung.
Zellvergiftung pharmakologisch verhindern
„Bei schwerstverletzten Trauma-Patienten auf Intensivstationen können die C. difficile-Toxine zudem zu posttraumatischen Komplikationen führen“, erklärt Papatheodorou, zu dessen Forschungsschwerpunkten die zelluläre Aufnahme und Wirkweise bakterieller Giftstoffe zählt. Ziel eines Kooperationsprojekts mit der Universität von Costa Rica war es nun, die Zellvergiftung durch C. difficile pharmakologisch zu verhindern. „Der Angriffspunkt, um die Giftstoffe des Bakteriums gezielt zu hemmen, ist ihre Abhängigkeit von Cholesterin in der Zellmembran der Wirtszellen“, so Professor Holger Barth. Der Leiter des Instituts für Experimentelle und Klinische Pharmakologie, Toxikologie und Naturheilkunde, der die Rolle bakterieller Toxine im Bereich der Traumatoxikologie im Ulmer SFB 1149 untersucht, hat die Studie [3] gemeinsam mit Professor Papatheodorou koordiniert. „Senkt man also den Cholesterin-Spiegel mit Medikamenten ab, gelangen TcdA und TcdB weniger effizient in die Zellen – und deren Vergiftung bleibt aus.“
Prinzip des „Drug Repurposing“ genutzt
Auf der Suche nach geeigneten Wirkstoffen bediente man sich dem Prinzip des „Drug Repurposing“, also der Erprobung bereits bekannter und lizenzierter Medikamente. Vorteile sind kürzere Weiterentwicklungs- und Zulassungszeiten sowie ein geringeres Risiko für unerwünschte Wirkungen. Die Idee, ausgerechnet Amiodaron zu untersuchen, hatte die Medizin-Doktorandin Judith Schumacher. „Dieses Medikament wird eigentlich als Antiarrhythmikum zur Behandlung von Herzrhythmusstörungen eingesetzt“, erklärt Schumacher, die am Institut für Experimentelle und Klinische Pharmakologie, Toxikologie und Naturheilkunde promoviert. „Meine Literaturrecherche hatte hervorgebracht, dass es Cholesterin-senkend wirkt. Wir prüften daher, ob eine Vorinkubation mit Amiodaron kultivierte Zellen auch vor einer Vergiftung mit TcdA und TcdB schützen kann.“
Einsatz von künstlichen Darmorganoiden
In ihren Experimenten untersuchten die Forscherinnen und Forscher kultivierte Säugetier- und Humanzellen. Schlüsselergebnisse überprüften sie an künstlichen Darmorganoiden – von der Ulmer Core Facility „Organoids“ zur Verfügung gestellt –, die als Alternative zum Tierversuch dreidimensionale Modelle des menschlichen Darms darstellen. Mittels Licht- und Fluoreszenzmikroskopie machten die Wissenschaftlerinnen und Wissenschaftler sowohl die Wirkung der C. difficile-Toxine auf kultivierte Zellen und Darmorganoide als auch den Hemmeffekt durch Amiodaron sichtbar. „Unsere Grundannahme, dass Amiodaron aufgrund seiner Cholesterin-senkenden Wirkung in Zellen als Hemmstoff für TcdA und TcdB aus C. difficile infrage kommt, konnte dabei bestätigt werden“, so Schumacher.
Klinische Studien benötigt
Es wurde zudem festgestellt, dass Amiodaron die Toxine noch über einen weiteren Mechanismus hemmt. „Um ihren toxischen Anteil in das Zellinnere zu transportieren, bilden die Toxine eine Membranpore“, so Papatheodorou. „Unseren Daten nach hemmt Amiodaron diesen Vorgang, indem es direkt mit dieser Membranpore wechselwirkt – selbst bei TcdA- und TcdB-Varianten aus einem besonders virulenten und epidemisch auftretenden C. difficile-Stamm.“ Die zunehmende Resistenz des Bakteriums gegen Antibiotika mache die Behandlung entsprechender Erkrankungen und posttraumatischer Komplikationen zunehmend schwer, so der Forscher. „Das Herzmedikament Amiodaron könnte eine Begleittherapie von C. difficile-assoziierten Erkrankungen darstellen, die aber zunächst noch in klinischen Studien untersucht werden muss.“ Unterstützt wurde das Projekt durch Drittmittel der Deutschen Forschungsgemeinschaft (DFG).
Quelle: idw/Uni Ulm
Artikel teilen